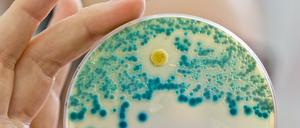
Eine Indikatorkulturplatte zum Nachweis von resistenten Bakterien.

Baku will um jeden Preis beeindrucken. Und gibt dabei viele Rätsel auf. Wer die Seele Aserbaidschans finden will, muss sich aufmachen in den Kaukasus.

Baku will um jeden Preis beeindrucken. Und gibt dabei viele Rätsel auf. Wer die Seele Aserbaidschans finden will, muss sich aufmachen in den Kaukasus.

Schwere Erbleiden verhindern, Schutz vor HIV: Der Ethikrat beriet erstmals, ob und wann das Erbgut von Embryonen verändert werden darf.

Österreich dominiert das Spiel gegen Island lange klar. Doch nach frühem Rückstand reicht es nur zu einem Tor - zu wenig, um im Turnier zu verbleiben.

Unser Europa: Das erste deutsch-polnische Geschichtsbuch soll Schülern beider Länder helfen, sich von Stereotypen zu befreien, sagt Polens Außenminister Waszczykowski.

Die einen fürchten sich vor dem "Menschen nach Maß", die anderen schwärmen von ungeahnten medizinischen Möglichkeiten. Aber wenn es um Crispr - und damit die Genchirurgie - geht, sind weder Hype noch Panikmache angemessen. Plädoyer für eine sachliche Debatte.

Die New York Times lobt den Räuberspielplatz, ein Familiencafé gibt's auch. Und am Hafen findet ein altes Haus einen neuen Nutzer. Unsere Spandau-Tipps der Woche.

Bei Google Street View ist der Zaun schon 2008 zu sehen. Wird Zeit für die Frage, ob den mal jemand wegräumt. Ja, sagt der Senat - und verrät auch wann.

Von Ostkreuz bis Mexikoplatz, von Staaken bis zum Märkischen Viertel: Das Parlament soll sich mit dem Bau neuer U-Bahn-Strecken befassen.

Sumak, Berberitzen oder Nigella: Mit Yotam Ottolenghi und Ali Güngörmüs zogen neue Aromen in deutsche Küchen. Wie kocht man damit? Wo kauft man sie? Eine Gebrauchsanweisung.

Die B-Juniorinnen von Turbine Potsdam sind zum elften Mal deutscher Meister. Für die Verantwortlichen des Klubs geht mit den Nachwuchserfolgen zugleich eine Herausforderung und Aufgabe einher.
Resistenzen gegen Antibiotika sind in der Medizin ein zunehmendes Problem. Neue Projekte und Konzepte sollen sie verhindern.

„Es geht so viel Energie von dort aus": Claus Kleber dokumentiert, wie die „Schöne neue Welt“ des Silicon Valley unsere Zukunft bestimmt.

„Es geht so viel Energie von dort aus": Claus Kleber dokumentiert, wie die „Schöne neue Welt“ des Silicon Valley unsere Zukunft bestimmt.

Italiens Krise, ganz privat: „Ein neues Leben“ wirft einen Blick in den Salento und zeigt die euorpäische Krise aus der Sicht von drei Frauen.

Viel Geld verschwand in Bauten wie dem Krematorium Baumschulenweg. Nun will sie Berlin zurückkaufen.

Wissenschaftler schlagen Alarm: Ein eingeschleppter Erreger könnte viele Amphibien ausrotten.

Zivilisierte demokratische Staaten setzen sich heute aus vielen Völkern zusammen. Wer dagegen seinen Begriff der Nation auf ethnischer Identität gründet, landet schnell bei Blut und Boden.

In den mächtigen Hügelgräbern der frühen Kelten wurden nicht nur Männer bestattet, fanden Prähistorikerinnen heraus.

Immer mehr Menschen auf der Welt haben einen getrübten Blick auf den nächtlichen Sternenhimmel. Das zeigt eine neue Studie, an der auch ein Potsdamer Wissenschaftler beteiligt war. Über die Ursachen.

Xenophobie hat auch biologische Wurzeln. Doch das ist kein Grund, sie zu rechtfertigen oder zu resignieren. Ein Kommentar.

Sonnenschutz ist wichtig. Aber Eltern und Kinder nervt das alltägliche Eincremen. Experten geben Tipps, wie Familien mit der lästigen Prozedur warm werden.

Ob bei Aldi, Dussmann oder Tönnies: Gibt es Streit im Familienunternehmen, steht viel auf dem Spiel – nicht selten wird der Betrieb am Ende zerlegt.

In Marzahn entsteht der erste Modulbau für Flüchtlinge – mit Wänden aus einem märkischen Werk. Sozialsenator Mario Czaja (CDU) fuhr dort dankbar vorbei.

Beim Unicef-Benefizkonzert in der ausverkauften Waldbühne spielten die Beatsteaks, Seeed, Cro und viele andere ohne Honorar.

Neue Immuntherapien gegen Krebs wecken große Hoffnungen. Doch bisher helfen sie längst nicht jedem Patienten. Berliner Forscher wollen nun eine personalisierte Variante der T-Zell-Therapie erproben.

Keine Höhenflüge mehr und keine Flügelkämpfe: Was die Berliner Grünen im Wahlkampf um das Abgeordnetenhaus anders machen wollen - und welche Gefahren ihnen drohen.

Erotisches Lächeln, klassisches Profil: Eine Ausstellung in Wörlitz spürt dem Faszinosum der Lady Hamilton nach.
Der Zeithistoriker Frank Bösch spricht im Interview über die periphere Lage der Potsdamer Universitäts-Standorte, die ungewöhnliche Geschichte der Hochschule und das gute Betreuungsverhältnis.

Kenne das Risiko: Bei Brustkrebspatientinnen können neue Tests den Krebstyp bestimmen - und so vielen Frauen eine Chemotherapie ersparen.

Die Bezirksbürgermeisterinnen Monika Herrmann und Birgit Monteiro übernehmen die Patenschaft für Lolek und Bolek - die kleinen Sichuan-Takine im Lichtenberger Tierpark.

Frankreich trifft Deutschland: Eindrücke vom Festival Jazzdor in der Berliner Kulturbrauerei - unter anderem mit Joachim Kühn und Émile Parisien.

Eine neue Ausstellung soll die einstige Stasi-Zentrale als Ort der Geschichte erlebbar machen. Dabei soll’s aber nicht bleiben.

Viele Eltern beschäftigen sich ungern mit dem Tod. Aber es ist wichtig, Kinder mit dem Thema vertraut zu machen. Und zwar bevor in ihrem Umfeld jemand stirbt.

Angst ist das Gefühl einer diffusen Bedrohung, die Sorge, den Halt zu verlieren. Mit ihr umzugehen, ist eine Kunst – die den wenigsten gelingt. Selten war das deutlicher zu sehen. Unsere Blendle-Empfehlung.

Bakterien trotzen immer häufiger Colistin, einem der letzten Reserve-Antibiotika. Wie groß ist die Gefahr?
Erstmals ist der "Super"-Erreger auch in den USA festgestellt worden. Das Bakterium ist gegen jedes Antibiotikum resistent.

Vor der Verleihung der Deutschen Filmpreise: Burghart Klaußner ist mit dem Favoritenfilm „Der Staat gegen Fritz Bauer“ nominiert. Im Interview spricht der Schauspieler über die Kneipe seines Vaters, seine "Galerie deutscher Männer" und die Kunst des Verschwindens.

Er ist durch PayPal und Facebook zum Milliardär geworden. Jetzt hat Peter Thiel in ein privateres Projekt investiert. Ein Porträt.

Im Laufe eines Lebens können Blutbahnen durch Ablagerungen verstopfen - wer das zu spät bemerkt, dem droht ein INFARKT. Mit einem Katheter dringen Ärzte bis zur verengten Ader vor.

Die Geschlechterforscherin Vera Regitz-Zagrosek erklärt, warum Frauen bei Herzkrankheiten aufholen. Und sie beklagt, dass trotzdem die Präventions- und Aufklärungskampagnen noch immer zu sehr auf Männer ausgerichtet sind.
öffnet in neuem Tab oder Fenster